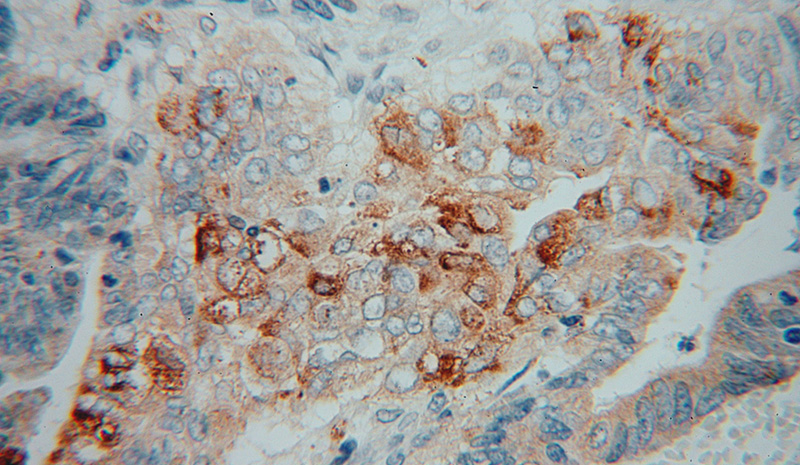
Immunohistochemical of paraffin-embedded human colon cancer using Catalog No:113923(PLA2G12A antibody) at dilution of 1:50 (under 40x lens)

-
Product Name
PLA2G12A antibody
- Documents
-
Description
PLA2G12A Rabbit Polyclonal antibody. Positive IHC detected in human colon cancer tissue, human skeletal muscle tissue. Positive IF detected in HEK-293 cells. Positive WB detected in mouse skeletal muscle tissue, HEK-293 cells, mouse heart tissue, mouse kidney tissue. Observed molecular weight by Western-blot: 21-24 kDa
-
Tested applications
ELISA, WB, IHC, IF
-
Species reactivity
Human,Mouse,Rat; other species not tested.
-
Alternative names
GXII antibody; GXII sPLA2 antibody; phospholipase A2 antibody; group XIIA antibody; PLA2G12 antibody; PLA2G12A antibody; ROSSY antibody; sPLA2 XII antibody; UNQ2519/PRO6012 antibody
-
Isotype
Rabbit IgG
-
Preparation
This antibody was obtained by immunization of PLA2G12A recombinant protein (Accession Number: NM_030821). Purification method: Antigen affinity purified.
-
Clonality
Polyclonal
-
Formulation
PBS with 0.02% sodium azide and 50% glycerol pH 7.3.
-
Storage instructions
Store at -20℃. DO NOT ALIQUOT
-
Applications
Recommended Dilution:
WB: 1:500-1:5000
IHC: 1:20-1:200
IF: 1:20-1:200
-
Validations

mouse skeletal muscle tissue were subjected to SDS PAGE followed by western blot with Catalog No:113923(PLA2G12A antibody) at dilution of 1:1000

Immunohistochemical of paraffin-embedded human colon cancer using Catalog No:113923(PLA2G12A antibody) at dilution of 1:50 (under 10x lens)
Immunohistochemical of paraffin-embedded human colon cancer using Catalog No:113923(PLA2G12A antibody) at dilution of 1:50 (under 40x lens)

Immunofluorescent analysis of HEK-293 cells using Catalog No:113923(PLA2G12A Antibody) at dilution of 1:50 and Alexa Fluor 488-congugated AffiniPure Goat Anti-Rabbit IgG(H+L)
-
Background
PLA2G12A (or PLA2G12) gene encodes group XII secreted phospholipase A2 (sPLA2) which catalyzes the calcium-dependent hydrolysis of the 2-acyl groups in 3-sn-phosphoglycerides. Cellular arachidonate (AA) release and prostaglandin (PG) production is regulated by sPLA(2)s, groups III and XII. Group XII sPLA2 have relatively low specific activity and are structurally and functionally distinct from other sPLA2s. Cells transfected with group XII sPLA(2) exhibited abnormal morphology, suggesting a unique functional aspect of this enzyme. Role of sPLA2s as potential tumour biomarkers and therapeutic targets for various cancers have been reported.
-
References
- Takahashi S, Suzuki K, Watanabe Y. Phospholipase A2 expression in coronary thrombus is increased in patients with recurrent cardiac events after acute myocardial infarction. International journal of cardiology. 168(4):4214-21. 2013.
- Suzuki K, Takahashi S, Watanabe K. The expression of groups IIE and V phospholipase A2 is associated with an increased expression of osteogenic molecules in human calcified aortic valves. Journal of atherosclerosis and thrombosis. 21(12):1308-25. 2014.
Related Products / Services
Please note: All products are "FOR RESEARCH USE ONLY AND ARE NOT INTENDED FOR DIAGNOSTIC OR THERAPEUTIC USE"
